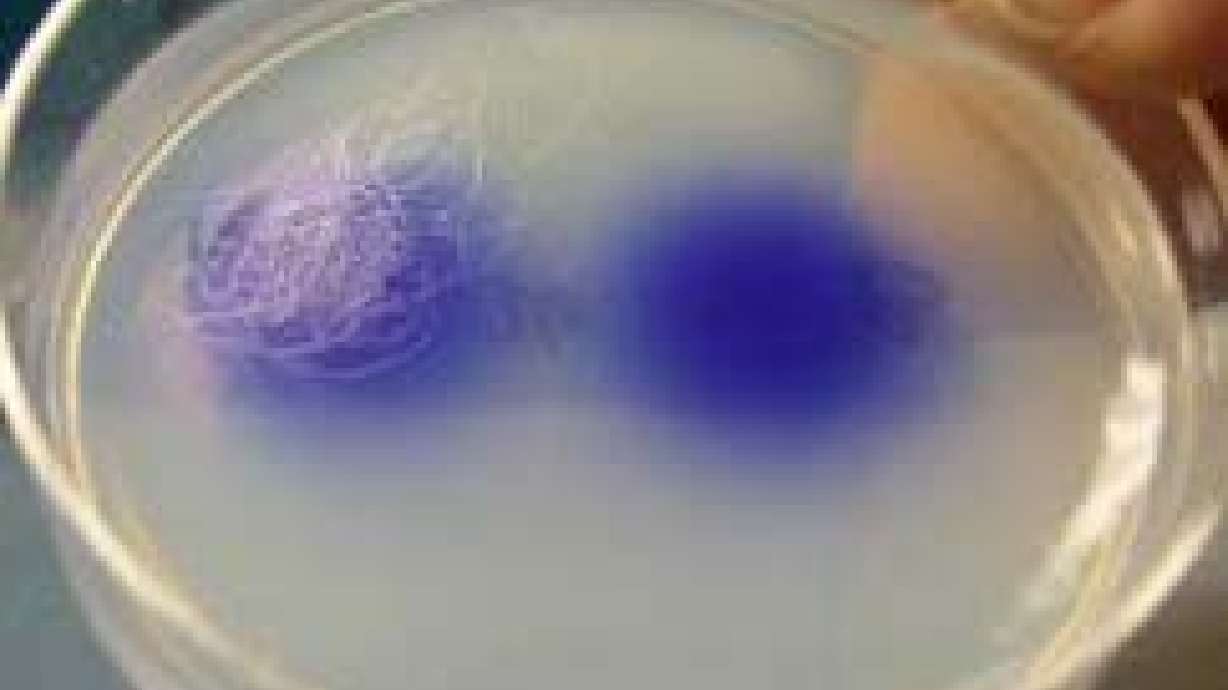
U of U Scientists Modify Sexual Behavior in Worms

Estimated read time: 2-3 minutes
This archived news story is available only for your personal, non-commercial use. Information in the story may be outdated or superseded by additional information. Reading or replaying the story in its archived form does not constitute a republication of the story.
Paul Nelson, KSL NewsradioA study from the University of Utah is being featured in the latest issue of Current Biology magazine. But it may sound very strange to a lot of us.
Researchers at the U of U have made a groundbreaking discovery in how the brain works, making major modifications in the behavior of worms. One side effect: they made worms gay.
Researcher Jamie White said, "We took a worm that looks like a female and because it has a male nervous system, we engineered that animal to have the male behaviors."
If you're thinking worms were asexual, well, I thought the same thing. However White says these worms, which you may see on rotting fruit, do have two sexes, a male, and a hermaphroditic female. The big question is, how can you tell they're attracted to the same sex?
"They don't slide their foot under the bathroom stall, do they?" I asked.
"No," White said.
"Rainbow flags on a bumper sticker?" I asked.
White told me, "It's a little more esoteric to get a readout of the behavior. Basically, what we do is… these worms in the laboratory on a pad of… "
This explanation went on for a while, but basically they took female pheromones, put them in the dish, and the genetically altered females flocked to them. To be fair, after the worms were altered, they showed all male behaviors, not just sexual preference. Some people may ask, what's the point of this?
"The overall question is to look at what generates behavior," Nelson said.
So, is the brain in charge of behavior, or do gender specific hormones control the brain? The answer: It's the brain. It's all in the brain. Gay rights advocates say this could help put to rest one part of the debate over homosexuality.
Utah Pride Center communications intern Yana Walton said, "People that consider it a choice, it's going to call that into question the more scientific body we have."
Walton says people shouldn't look at the study as saying scientists are one step closer to "curing" gayness.
"I think the objective of the study was to determine not if gayness can be ‘cured,' but, what actually would cause same sex attraction in genes," Walton said.
Researchers aren't drawing any parallels between worm behavior and human behavior.